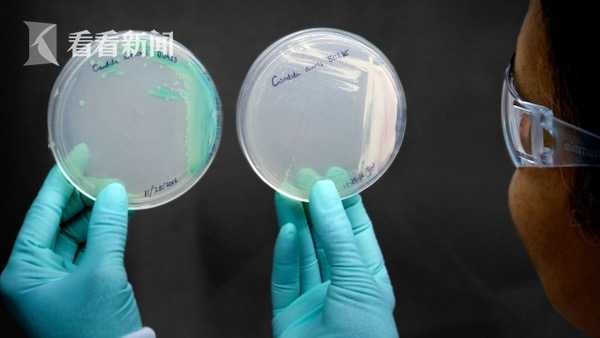
能人传人且致命！美国出现“超级真菌”群体感染 已致4人死亡休闲区蓝鸢梦想 - Www.slyday.coM

据美国疾病控制和预防中心表示,近期,美国得克萨斯州科林县达拉斯地区的两家医院出现“超级真菌”群体感染事件,目前已导致22人感染,其中4人死亡,有两名死者生前对全部三种抗真菌疗法均表现出抗药性。
这种“超级真菌”也叫作“耳念珠菌”,因具有超强耐药性而被称为“超级真菌”,且有无法治疗的特点。近期的感染病例显示,“超级真菌”能在人与人之间传染,对病情严重的住院患者或疗养院病人构成致命威胁。

据报道,在今年1月至4月间,美国首都华盛顿特区和达拉斯地区陆续通报“超级真菌”感染事件。在华盛顿特区,一家主要接收重病患者的疗养院出现了101例“超级真菌”感染病例,有3名患者对全部三种抗真菌疗法均表现出抗药性,其中一名患者不幸身亡。4月以后,这两地仍然不时出现感染病例。

“超级真菌”最早在2009年被发现,随后迅速扩散至十多个国家和地区。美国疾控中心称,在感染了进攻性“超级真菌”的患者中,死亡率超过三分之一。
(编辑:刘清扬)
